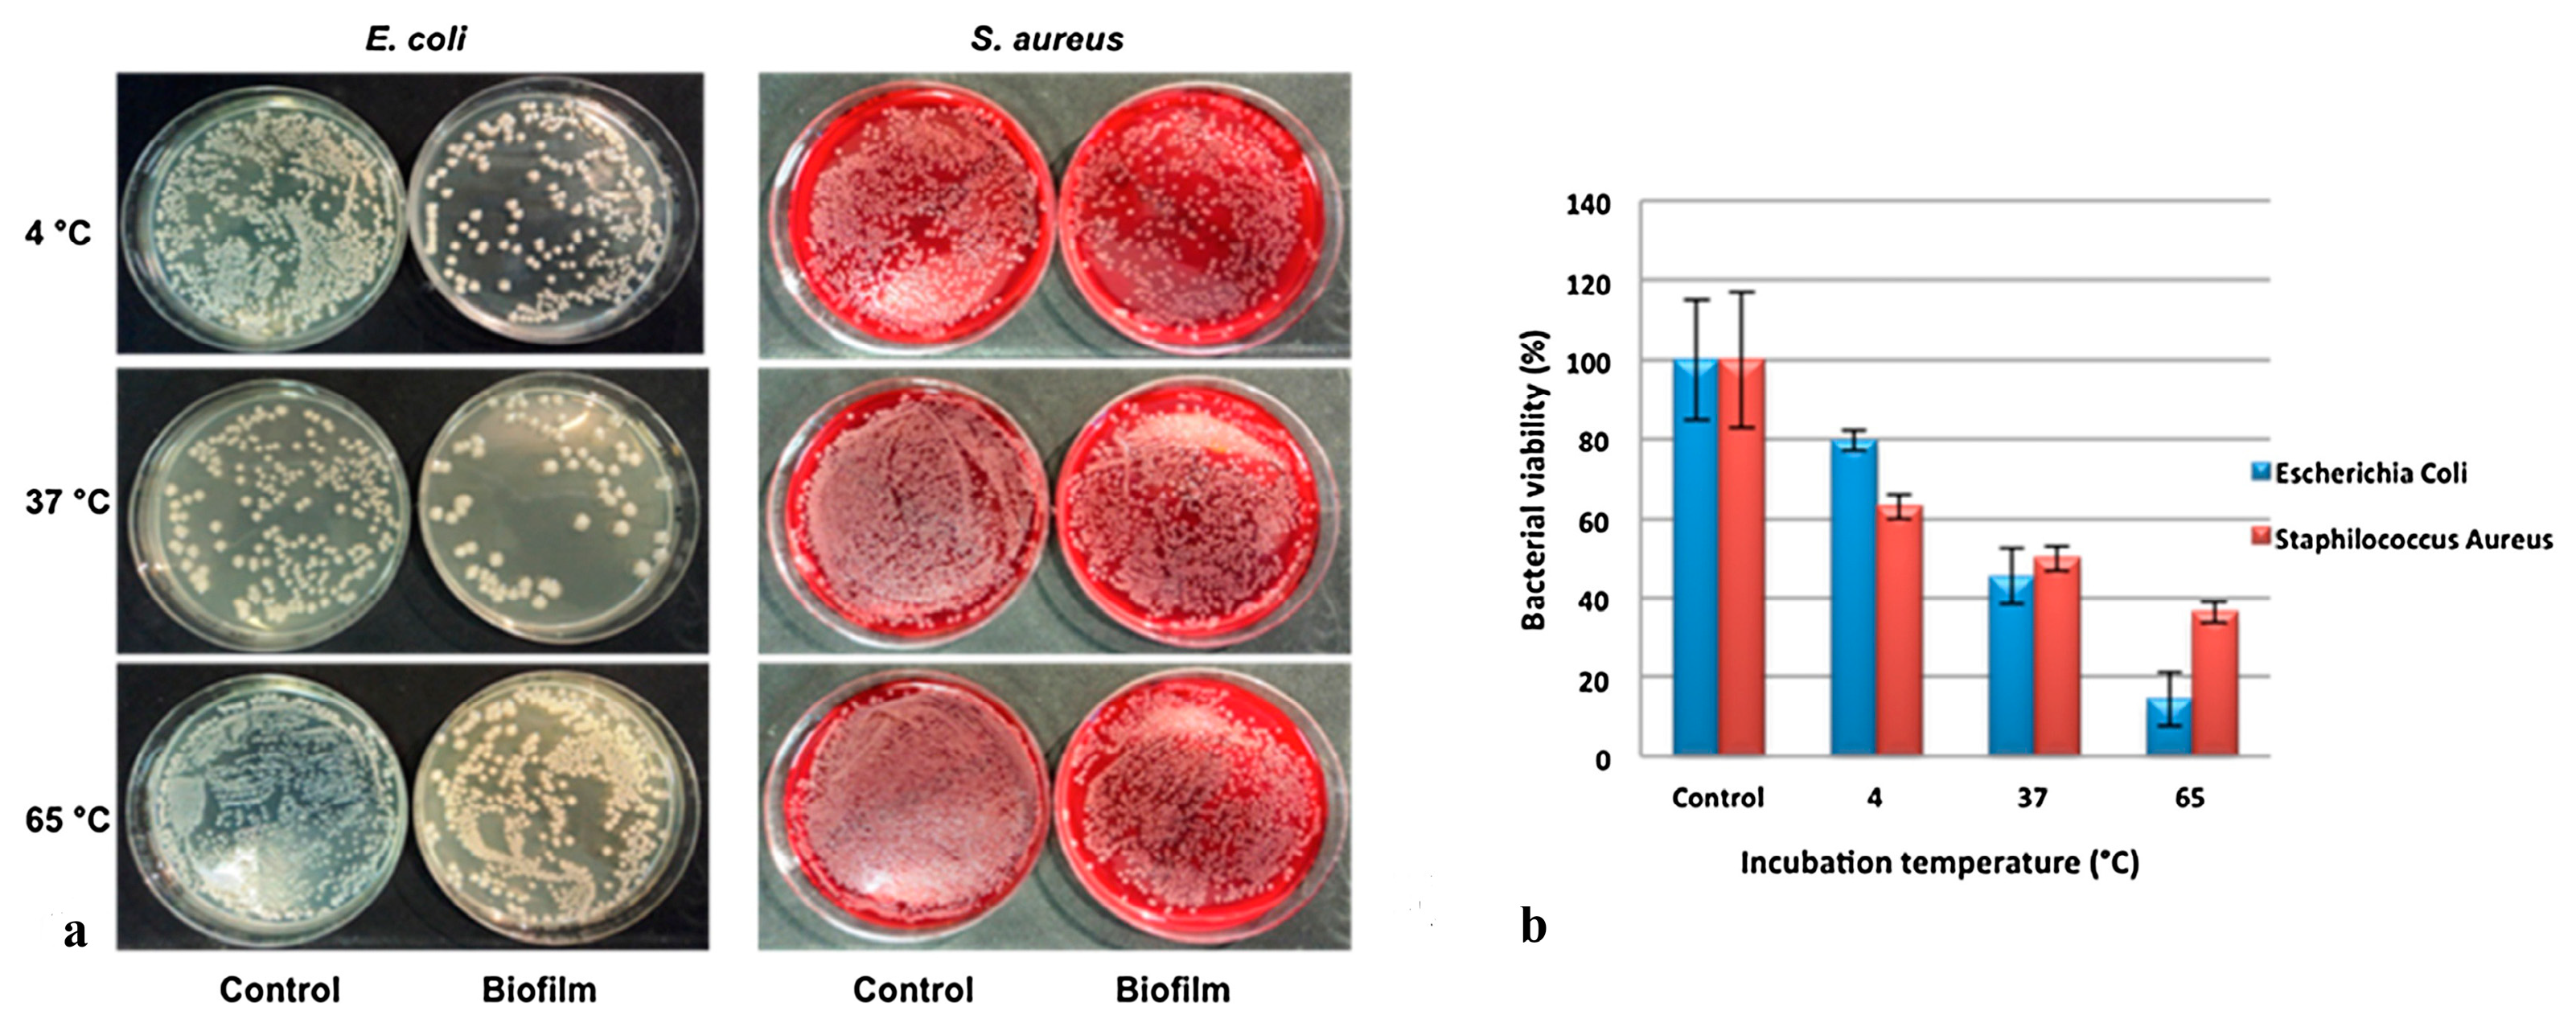
Ijms 24 04801 g007 Ijms 24 04801 g007

Halloysite Nanotubes and Sepiolite for Health Applications
Abstract
1. Introduction
2. One Dimensional Clays Mineral: Sepiolite and Halloysite Nanotubes
2.1. Sepiolite
2.2. Halloysite Nanotubes
3. One Dimensional Clays Biocompatibility
3.1. Sepiolite Biocompatibility
3.2. Halloysite Biocompatibility
4. Halloysite and Sepiolite for Biomedical Applications
4.1. Drug Delivery
4.2. Gene Delivery
4.3. Wound Healing
4.4. Antimicrobial Activity
5. Conclusions
Funding
Institutional Review Board Statement
Informed Consent Statement
Data Availability Statement
Acknowledgments
Conflicts of Interest
References
- Tian, G.; Han, G.; Wang, F.; Liang, J. 3—Sepiolite Nanomaterials: Structure, Properties and Functional Applications. In Nanomaterials from Clay Minerals; Wang, A., Wang, W., Eds.; Elsevier: Amsterdam, The Netherlands, 2019; pp. 135–201. [Google Scholar] [CrossRef]
- Biddeci, G.; Spinelli, G.; Colomba, P.; Di Blasi, F. Nanomaterials: A Review about Halloysite Nanotubes, Properties, and Application in the Biological Field. Int. J. Mol. Sci. 2022, 23, 11518. [Google Scholar] [CrossRef] [PubMed]
- Choy, J.-H.; Choi, S.-J.; Oh, J.-M.; Park, T. Clay minerals and layered double hydroxides for novel biological applications. Appl. Clay Sci. 2007, 36, 122–132. [Google Scholar] [CrossRef]
- Aguzzi, C.; Cerezo, P.; Viseras, C.; Caramella, C. Use of clays as drug delivery systems: Possibilities and limitations. Appl. Clay Sci. 2007, 36, 22–36. [Google Scholar] [CrossRef]
- Viseras, C.; Aguzzi, C.; Cerezo, P.; Lopez-Galindo, A. Uses of clay minerals in semisolid health care and therapeutic products. Appl. Clay Sci. 2007, 36, 37–50. [Google Scholar] [CrossRef]
- Viseras, C.; Cerezo, P.; Sanchez, R.; Salcedo, I.; Aguzzi, C. Current challenges in clay minerals for drug delivery. Appl. Clay Sci. 2010, 48, 291–295. [Google Scholar] [CrossRef]
- Carretero, M.I.; Pozo, M. Clay and non-clay minerals in the pharmaceutical industry: Part I. Excipients and medical applications. Appl. Clay Sci. 2009, 46, 73–80. [Google Scholar] [CrossRef]
- Lin, F.H.; Lee, Y.H.; Jian, C.H.; Wong, J.M.; Shieh, M.J.; Wang, C.Y. A study of purified montmorillonite intercalated with 5-fluorouracil as drug carrier. Biomaterials 2002, 23, 1981–1987. [Google Scholar] [CrossRef]
- Vergaro, V.; Abdullayev, E.; Lvov, Y.M.; Zeitoun, A.; Cingolani, R.; Rinaldi, R.; Leporatti, S. Cytocompatibility and Uptake of Halloysite Clay Nanotubes. Biomacromolecules 2010, 11, 820–826. [Google Scholar] [CrossRef]
- Verma, N.K.; Moore, E.; Blau, W.; Volkov, Y.; Ramesh Babu, P. Cytotoxicity evaluation of nanoclays in human epithelial cell line A549 using high content screening and real-time impedance analysis. J. Nanoparticle Res. 2012, 14, 1137. [Google Scholar] [CrossRef]
- Liu, H.-Y.; Du, L.; Zhao, Y.-T.; Tian, W.-Q. In Vitro Hemocompatibility and Cytotoxicity Evaluation of Halloysite Nanotubes for Biomedical Application. J. Nanomater. 2015, 2015, 685323. [Google Scholar] [CrossRef]
- Sawicka, D.; Zapor, L.; Chojnacka-Puchta, L.; Miranowicz-Dzierzawska, K. The in vitro toxicity evaluation of halloysite nanotubes (HNTs) in human lung cells. Toxicol. Res. 2021, 37, 301–310. [Google Scholar] [CrossRef] [PubMed]
- Biddeci, G.; Spinelli, G.; Massaro, M.; Riela, S.; Bonaccorsi, P.; Barattucci, A.; Di Blasi, F. Study of Uptake Mechanisms of Halloysite Nanotubes in Different Cell Lines. Int. J. Nanomed. 2021, 16, 4755–4768. [Google Scholar] [CrossRef] [PubMed]
- Olmo, N.; Turnay, J.; Gavilanes, J.G.; Lizarbe, M.A.; Herrera, J.I. Subcutaneous and intramuscular implantation of sepiolite-collagen complexes. J. Mater. Sci. Mater. Med. 1992, 3, 239–244. [Google Scholar] [CrossRef]
- Brooks, D.A.; Piétrement, O.; Dardillac, E.; Jayantha, A.; Lores Guevara, M.A.; Castro-Smirnov, F.A.; Aranda, P.; Ruiz-Hitzky, E.; Lopez, B.S. Impact of Increased Sonication-Induced Dispersion of Sepiolite on Its Interaction with Biological Macromolecules and Toxicity/Proliferation in Human Cells. ACS Omega 2023, 8, 1026–1036. [Google Scholar] [CrossRef]
- Chen, P.; Xie, F.; Tang, F.; McNally, T. Cooperative Effects of Cellulose Nanocrystals and Sepiolite When Combined on Ionic Liquid Plasticised Chitosan Materials. Polymers 2021, 13, 571. [Google Scholar] [CrossRef]
- Ragu, S.; Dardillac, E.; Brooks, D.A.; Castro-Smirnov, F.A.; Aranda, P.; Ruiz-Hitzky, E.; Lopez, B.S. Responses of human cells to sepiolite interaction. Appl. Clay Sci. 2020, 194, 105655. [Google Scholar] [CrossRef]
- Wang, Q.; Zhang, J.; Wang, A. Preparation and characterization of a novel pH-sensitive chitosan-g-poly (acrylic acid)/attapulgite/sodium alginate composite hydrogel bead for controlled release of diclofenac sodium. Carbohydr. Polym. 2009, 78, 731–737. [Google Scholar] [CrossRef]
- Ruiz-Hitzky, E. Molecular access to intracrystalline tunnels of sepiolite. J. Mater. Chem. 2001, 11, 86–91. [Google Scholar] [CrossRef]
- Santaren, J.; Sanz, J.; Ruiz-Hitzky, E. Structural Fluorine in Sepiolite. Clays Clay Miner. 1990, 38, 63–68. [Google Scholar] [CrossRef]
- Suárez, M.; García-Romero, E. Variability of the surface properties of sepiolite. Appl. Clay Sci. 2012, 67–68, 72–82. [Google Scholar] [CrossRef]
- Singer, A.; Galan, E. Palygorskite-Sepiolite: Occurrences, Genesis and Uses; Elsevier: Amsterdam, The Netherlands, 2000. [Google Scholar]
- Murray, H.H.; Pozo, M.; Galán, E. Chapter 4—An Introduction to Palygorskite and Sepiolite Deposits—Location, Geology and Uses. In Developments in Clay Science; Galàn, E., Singer, A., Eds.; Elsevier: Amsterdam, The Netherlands, 2011; Volume 3, pp. 85–99. [Google Scholar]
- López-Galindo, A.; Bauluz, B. Mineralogical and chemical characterization of the sepiolite/Mg-smectite deposit at Mara (Calatayud basin, Spain). Eur. J. Miner. 1998, 10, 367–383. [Google Scholar] [CrossRef]
- Yalçin, H.; Bozkaya, Ö. Sepiolite–palygorskite occurrences in Turkey. In Developments in Clay Science; Elsevier: Amsterdam, The Netherlands, 2011; Volume 3, pp. 175–200. [Google Scholar]
- Zhuang, G.; Gao, J.; Chen, H.; Zhang, Z. A new one-step method for physical purification and organic modification of sepiolite. Appl. Clay Sci. 2018, 153, 1–8. [Google Scholar] [CrossRef]
- Cannings, F.R. Infrared study of hydroxyl groups on sepiolite. J. Phys. Chem. 1968, 72, 1072–1074. [Google Scholar] [CrossRef]
- Serna, C.; Ahlrichs, J.L.; Serratosa, J.M. Folding in Sepiolite Crystals. Clays Clay Miner. 1975, 23, 452–457. [Google Scholar] [CrossRef]
- Prost, R. Infrared study of the interactions between the different kinds of water molecules present in sepiolite. Spectrochim. Acta Part A Mol. Spectrosc. 1975, 31, 1497–1499. [Google Scholar] [CrossRef]
- Fajdek-Bieda, A.; Wróblewska, A.; Miądlicki, P.; Szymańska, A.; Dzięcioł, M.; Booth, A.M.; Michalkiewicz, B. Influence of Technological Parameters on the Isomerization of Geraniol Using Sepiolite. Catal. Lett. 2020, 150, 901–911. [Google Scholar] [CrossRef]
- Castro-Smirnov, F.A.; Piétrement, O.; Aranda, P.; Bertrand, J.-R.; Ayache, J.; Le Cam, E.; Ruiz-Hitzky, E.; Lopez, B.S. Physical interactions between DNA and sepiolite nanofibers, and potential application for DNA transfer into mammalian cells. Sci. Rep. 2016, 6, 36341. [Google Scholar] [CrossRef] [PubMed]
- Ahlrichs, J.L.; Serna, C.; Serratosa, J.M. Structural Hydroxyls in Sepiolites. Clays Clay Miner. 1975, 23, 119–124. [Google Scholar] [CrossRef]
- Suárez, M.; García-Romero, E. Chapter 2—Advances in the Crystal Chemistry of Sepiolite and Palygorskite. In Developments in Clay Science; Galàn, E., Singer, A., Eds.; Elsevier: Amsterdam, The Netherlands, 2011; Volume 3, pp. 33–65. [Google Scholar]
- Komarneni, S.; Fyfe, C.A.; Kennedy, G.J. Detection of nonequivalent Si sites in sepiolite and palygorskite by solid-state 29Si magic angle spinning-nuclear magnetic resonance. Clays Clay Miner. 1986, 34, 99–102. [Google Scholar] [CrossRef]
- Wicklein, B.; Darder, M.; Aranda, P.; Ruiz-Hitzky, E. Bio-organoclays Based on Phospholipids as Immobilization Hosts for Biological Species. Langmuir 2010, 26, 5217–5225. [Google Scholar] [CrossRef]
- Alcântara, A.C.S.; Darder, M.; Aranda, P.; Ruiz-Hitzky, E. Zein–Fibrous Clays Biohybrid Materials. Eur. J. Inorg. Chem. 2012, 2012, 5216–5224. [Google Scholar] [CrossRef]
- Fernandes, F.M.; Ruiz, A.I.; Darder, M.; Aranda, P.; Ruiz-Hitzky, E. Gelatin-clay bio-nanocomposites: Structural and functional properties as advanced materials. J. Nanosci. Nanotechnol. 2009, 9, 221–229. [Google Scholar] [CrossRef] [PubMed]
- Fernandes, F.M.; Manjubala, I.; Ruiz-Hitzky, E. Gelatin renaturation and the interfacial role of fillers in bionanocomposites. Phys. Chem. Chem. Phys. PCCP 2011, 13, 4901–4910. [Google Scholar] [CrossRef] [PubMed]
- Ruiz-Hitzky, E.; Darder, M.; Fernandes, F.M.; Wicklein, B.; Alcântara, A.C.S.; Aranda, P. Fibrous clays based bionanocomposites. Prog. Polym. Sci. 2013, 38, 1392–1414. [Google Scholar] [CrossRef]
- Alcântara, A.C.S.; Darder, M.; Aranda, P.; Ruiz-Hitzky, E. Polysaccharide–fibrous clay bionanocomposites. Appl. Clay Sci. 2014, 96, 2–8. [Google Scholar] [CrossRef]
- Darder, M.; López-Blanco, M.; Aranda, P.; Aznar, A.J.; Bravo, J.; Ruiz-Hitzky, E. Microfibrous Chitosan−Sepiolite Nanocomposites. Chem. Mater. 2006, 18, 1602–1610. [Google Scholar] [CrossRef]
- Ruiz-Hitzky, E.; Darder, M.; Aranda, P.; del Burgo, M.Á.M.; del Real, G. Bionanocomposites as New Carriers for Influenza Vaccines. Adv. Mater. 2009, 21, 4167–4171. [Google Scholar] [CrossRef]
- Wilbourn, J.D.; McGregor, D.B.; Partensky, C.; Rice, J.M. IARC reevaluates silica and related substances. Environ. Health Perspect. 1997, 105, 756–759. [Google Scholar] [CrossRef]
- Neeraj, K.; Chandra, M. Basics of Clay Minerals and Their Characteristic Properties. In Clay and Clay Minerals; Do Nacimiento, G.M., Ed.; IntechOpen: Rijeka, Croatia, 2021; p. Ch. 2. [Google Scholar]
- Prishchenko, D.A.; Zenkov, E.V.; Mazurenko, V.V.; Fakhrullin, R.F.; Lvov, Y.M.; Mazurenko, V.G. Molecular dynamics of the halloysite nanotubes. Phys. Chem. Chem. Phys. 2018, 20, 5841–5849. [Google Scholar] [CrossRef]
- Santos, A.C.; Ferreira, C.; Veiga, F.; Ribeiro, A.J.; Panchal, A.; Lvov, Y.; Agarwal, A. Halloysite clay nanotubes for life sciences applications: From drug encapsulation to bioscaffold. Adv. Colloid Interface Sci. 2018, 257, 58–70. [Google Scholar] [CrossRef]
- Kotova, O.; Sun, S.; Kotova, E.; Ponariaydov, A.; Brodskaya, R. Aluminosilicates: Interphase boundary interactions and nature engineering of nanostructures. J. Phys. Conf. Ser. 2022, 2315, 012003. [Google Scholar] [CrossRef]
- Hasani, M.; Abdouss, M.; Shojaei, S. Nanocontainers for drug delivery systems: A review of Halloysite nanotubes and their properties. Int. J. Artif. Organs 2021, 44, 426–433. [Google Scholar] [CrossRef] [PubMed]
- Chow, W.S.; Tham, W.L.; Seow, P.C. Effects of maleated-PLA compatibilizer on the properties of poly(lactic acid)/halloysite clay composites. J. Thermoplast. Compos. Mater. 2013, 26, 1349–1363. [Google Scholar] [CrossRef]
- Joussein, E.; Petit, S.; Delvaux, B. Behavior of halloysite clay under formamide treatment. Appl. Clay Sci. 2007, 35, 17–24. [Google Scholar] [CrossRef]
- Lvov, Y.; Panchal, A.; Fu, Y.; Fakhrullin, R.; Kryuchkova, M.; Batasheva, S.; Stavitskaya, A.; Glotov, A.; Vinokurov, V. Interfacial Self-Assembly in Halloysite Nanotube Composites. Langmuir 2019, 35, 8646–8657. [Google Scholar] [CrossRef] [PubMed]
- Teo, Z.X.; Chow, W.S. Impact, Thermal, and Morphological Properties of Poly(Lactic Acid)/Poly(Methyl Methacrylate)/Halloysite Nanotube Nanocomposites. Polym. Plast. Technol. Eng. 2016, 55, 1474–1480. [Google Scholar] [CrossRef]
- Abdullayev, E.; Lvov, Y. Halloysite clay nanotubes as a ceramic “skeleton” for functional biopolymer composites with sustained drug release. J. Mater. Chem. B 2013, 1, 2894–2903. [Google Scholar] [CrossRef] [PubMed]
- Pereira, I.; Saleh, M.; Nunes, C.; Reis, S.; Veiga, F.; Paiva-Santos, A.C. Preclinical developments of natural-occurring halloysite clay nanotubes in cancer therapeutics. Adv. Colloid Interface Sci. 2021, 291, 102406. [Google Scholar] [CrossRef]
- Tarì, G.; Bobos, I.; Gomes, C.S.F.; Ferreira, J.M.F. Modification of Surface Charge Properties during Kaolinite to Halloysite-7Å Transformation. J. Colloid Interface Sci. 1999, 210, 360–366. [Google Scholar] [CrossRef]
- Hélio, A.D.; Maicon, P.L.; Thomas, H.; Luciana, G. Clay Mineral Nanotubes: Stability, Structure and Properties. In Stoichiometry and Materials Science; Alessio, I., Norlida, K., Eds.; IntechOpen: Rijeka, Croatia, 2012; Chapter 1. [Google Scholar]
- Guimarães, L.; Enyashin, A.N.; Seifert, G.; Duarte, H.A. Structural, Electronic, and Mechanical Properties of Single-Walled Halloysite Nanotube Models. J. Phys. Chem. C 2010, 114, 11358–11363. [Google Scholar] [CrossRef]
- Joo, Y.; Sim, J.H.; Jeon, Y.; Lee, S.U.; Sohn, D. Opening and blocking the inner-pores of halloysite. Chem. Commun. 2013, 49, 4519–4521. [Google Scholar] [CrossRef] [PubMed]
- Bugatti, V.; Sorrentino, A.; Gorrasi, G. Encapsulation of Lysozyme into halloysite nanotubes and dispersion in PLA: Structural and physical properties and controlled release analysis. Eur. Polym. J. 2017, 93, 495–506. [Google Scholar] [CrossRef]
- Albdiry, M.T.; Yousif, B.F. Role of silanized halloysite nanotubes on structural, mechanical properties and fracture toughness of thermoset nanocomposites. Mater. Des. 2014, 57, 279–288. [Google Scholar] [CrossRef]
- Yuan, P.; Southon, P.D.; Liu, Z.; Green, M.E.R.; Hook, J.M.; Antill, S.J.; Kepert, C.J. Functionalization of Halloysite Clay Nanotubes by Grafting with γ-Aminopropyltriethoxysilane. J. Phys. Chem. C 2008, 112, 15742–15751. [Google Scholar] [CrossRef]
- Tan, D.; Yuan, P.; Liu, D.; Du, P. Chapter 8—Surface Modifications of Halloysite. In Developments in Clay Science; Yuan, P., Thill, A., Bergaya, F., Eds.; Elsevier: Amsterdam, The Netherlands, 2016; Volume 7, pp. 167–201. [Google Scholar]
- Oberdörster, G.; Oberdörster, E.; Oberdörster, J. Nanotoxicology: An emerging discipline evolving from studies of ultrafine particles. Environ. Health Perspect. 2005, 113, 823–839. [Google Scholar] [CrossRef]
- De Jong, W.H.; Hagens, W.I.; Krystek, P.; Burger, M.C.; Sips, A.J.; Geertsma, R.E. Particle size-dependent organ distribution of gold nanoparticles after intravenous administration. Biomaterials 2008, 29, 1912–1919. [Google Scholar] [CrossRef]
- Rizvi, S.A.A.; Saleh, A.M. Applications of nanoparticle systems in drug delivery technology. Saudi Pharm. J. 2018, 26, 64–70. [Google Scholar] [CrossRef]
- Hirayama, D.; Iida, T.; Nakase, H. The Phagocytic Function of Macrophage-Enforcing Innate Immunity and Tissue Homeostasis. Int. J. Mol. Sci. 2017, 19, 92. [Google Scholar] [CrossRef]
- Franko, J.; McCall, J.L.; Barnett, J.B. Evaluating Macrophages in Immunotoxicity Testing. Methods Mol. Biol. 2018, 1803, 255–296. [Google Scholar] [CrossRef]
- Gomes, C.; Rautureau, M.; Poustis, J.; Gomes, J. Benefits and risks of clays and clay minerals to human health from ancestral to current times: A synoptic overview. Clays Clay Miner. 2021, 69, 612–632. [Google Scholar] [CrossRef]
- González-Tortuero, E.; Rodríguez-Beltrán, J.; Radek, R.; Blázquez, J.; Rodríguez-Rojas, A. Clay-induced DNA breaks as a path for genetic diversity, antibiotic resistance, and asbestos carcinogenesis. Sci. Rep. 2018, 8, 8504. [Google Scholar] [CrossRef] [PubMed]
- Yoshida, N.; Sato, M. Plasmid uptake by bacteria: A comparison of methods and efficiencies. Appl. Microbiol. Biotechnol. 2009, 83, 791–798. [Google Scholar] [CrossRef] [PubMed]
- Wilharm, G.; Lepka, D.; Faber, F.; Hofmann, J.; Kerrinnes, T.; Skiebe, E. A simple and rapid method of bacterial transformation. J. Microbiol. Methods 2010, 80, 215–216. [Google Scholar] [CrossRef] [PubMed]
- Castro-Smirnov, F.A.; Piétrement, O.; Aranda, P.; Le Cam, E.; Ruiz-Hitzky, E.; Lopez, B.S. Biotechnological applications of the sepiolite interactions with bacteria: Bacterial transformation and DNA extraction. Appl. Clay Sci. 2020, 191, 105613. [Google Scholar] [CrossRef]
- Castro-Smirnov, F.A.; Ayache, J.; Bertrand, J.-R.; Dardillac, E.; Le Cam, E.; Piétrement, O.; Aranda, P.; Ruiz-Hitzky, E.; Lopez, B.S. Cellular uptake pathways of sepiolite nanofibers and DNA transfection improvement. Sci. Rep. 2017, 7, 5586. [Google Scholar] [CrossRef]
- Piétrement, O.; Castro-Smirnov, F.A.; Le Cam, E.; Aranda, P.; Ruiz-Hitzky, E.; Lopez, B.S. Sepiolite as a New Nanocarrier for DNA Transfer into Mammalian Cells: Proof of Concept, Issues and Perspectives. Chem. Rec. 2018, 18, 849–857. [Google Scholar] [CrossRef]
- Denizeau, F.; Marion, M.; Chevalier, G.; Cote, M.G. Absence of genotoxic effects of nonasbestos mineral fibers. Cell Biol. Toxicol. 1985, 1, 23–32. [Google Scholar] [CrossRef]
- McConnochie, K.; Bevan, C.; Newcombe, R.G.; Lyons, J.P.; Skidmore, J.W.; Wagner, J.C. A study of Spanish sepiolite workers. Thorax 1993, 48, 370–374. [Google Scholar] [CrossRef]
- Maisanaba, S.; Pichardo, S.; Puerto, M.; Gutiérrez-Praena, D.; Cameán, A.M.; Jos, A. Toxicological evaluation of clay minerals and derived nanocomposites: A review. Environ. Res. 2015, 138, 233–254. [Google Scholar] [CrossRef]
- Fernandes, A.C.; Antunes, F.; Pires, J. Sepiolite based materials for storage and slow release of nitric oxide. New J. Chem. 2013, 37, 4052–4060. [Google Scholar] [CrossRef]
- Prinz Setter, O.; Segal, E. Halloysite nanotubes—The nano-bio interface. Nanoscale 2020, 12, 23444–23460. [Google Scholar] [CrossRef]
- Pasbakhsh, P.; Churchman, G.J.; Keeling, J.L. Characterisation of properties of various halloysites relevant to their use as nanotubes and microfibre fillers. Appl. Clay Sci. 2013, 74, 47–57. [Google Scholar] [CrossRef]
- Lazzara, G.; Bruno, F.; Brancato, D.; Sturiale, V.; D’Amico, A.G.; Miloto, S.; Pasbakhsh, P.; D’Agata, V.; Saccone, S.; Federico, C. Biocompatibility analysis of halloysite clay nanotubes. Mater. Lett. 2023, 336, 133852. [Google Scholar] [CrossRef]
- Long, Z.; Wu, Y.-P.; Gao, H.-Y.; Zhang, J.; Ou, X.; He, R.-R.; Liu, M. In vitro and in vivo toxicity evaluation of halloysite nanotubes. J. Mater. Chem. B 2018, 6, 7204–7216. [Google Scholar] [CrossRef] [PubMed]
- Ahmed, F.R.; Shoaib, M.H.; Azhar, M.; Um, S.H.; Yousuf, R.I.; Hashmi, S.; Dar, A. In-vitro assessment of cytotoxicity of halloysite nanotubes against HepG2, HCT116 and human peripheral blood lymphocytes. Colloids Surfaces B Biointerfaces 2015, 135, 50–55. [Google Scholar] [CrossRef] [PubMed]
- Luo, Y.; Humayun, A.; Murray, T.A.; Kemp, B.S.; McFarland, A.; Liu, X.; Mills, D.K. Cellular Analysis and Chemotherapeutic Potential of a Bi-Functionalized Halloysite Nanotube. Pharmaceutics 2020, 12, 962. [Google Scholar] [CrossRef]
- Taheri-Ledari, R.; Zhang, W.; Radmanesh, M.; Cathcart, N.; Maleki, A.; Kitaev, V. Plasmonic photothermal release of docetaxel by gold nanoparticles incorporated onto halloysite nanotubes with conjugated 2D8-E3 antibodies for selective cancer therapy. J. Nanobiotechnol. 2021, 19, 239. [Google Scholar] [CrossRef]
- Dube, S.; Rawtani, D.; Khatri, N.; Parikh, G. A deep delve into the chemistry and biocompatibility of halloysite nanotubes: A new perspective on an idiosyncratic nanocarrier for delivering drugs and biologics. Adv. Colloid Interface Sci. 2022, 309, 102776. [Google Scholar] [CrossRef]
- Senapati, S.; Mahanta, A.K.; Kumar, S.; Maiti, P. Controlled drug delivery vehicles for cancer treatment and their performance. Signal Transduct. Target. Ther. 2018, 3, 7. [Google Scholar] [CrossRef]
- Zhou, C.H.; Keeling, J. Fundamental and applied research on clay minerals: From climate and environment to nanotechnology. Appl. Clay Sci. 2013, 74, 3–9. [Google Scholar] [CrossRef]
- Moraes, J.D.D.; Bertolino, S.R.A.; Cuffini, S.L.; Ducart, D.F.; Bretzke, P.E.; Leonardi, G.R. Clay minerals: Properties and applications to dermocosmetic products and perspectives of natural raw materials for therapeutic purposes—A review. Int. J. Pharm. 2017, 534, 213–219. [Google Scholar] [CrossRef] [PubMed]
- Zhang, A.; Jung, K.; Li, A.; Liu, J.; Boyer, C. Recent advances in stimuli-responsive polymer systems for remotely controlled drug release. Prog. Polym. Sci. 2019, 99, 101164. [Google Scholar] [CrossRef]
- Adepu, S.; Ramakrishna, S. Controlled Drug Delivery Systems: Current Status and Future Directions. Molecules 2021, 26, 5905. [Google Scholar] [CrossRef] [PubMed]
- Ragu, S.; Piétrement, O.; Lopez, B.S. Binding of dna to natural sepiolite: Applications in biotechnology and perspectives. Clays Clay Miner. 2021, 69, 633–640. [Google Scholar] [CrossRef]
- Carazo, A.; Macáková, K.; Matoušová, K.; Krčmová, L.K.; Protti, M.; Mladěnka, P. Vitamin A Update: Forms, Sources, Kinetics, Detection, Function, Deficiency, Therapeutic Use and Toxicity. Nutrients 2021, 13, 1703. [Google Scholar] [CrossRef]
- Calabrese, I.; Turco Liveri, M.L.; Ferreira, M.J.; Bento, A.; Vaz, P.D.; Calhorda, M.J.; Nunes, C.D. Porous materials as delivery and protective agents for Vitamin A. RSC Adv. 2016, 6, 66495–66504. [Google Scholar] [CrossRef]
- Dinçer, A.; Becerik, S.; Aydemir, T. Immobilization of tyrosinase on chitosan–clay composite beads. Int. J. Biol. Macromol. 2012, 50, 815–820. [Google Scholar] [CrossRef]
- Liu, K.-H.; Liu, T.-Y.; Chen, S.-Y.; Liu, D.-M. Drug release behavior of chitosan–montmorillonite nanocomposite hydrogels following electrostimulation. Acta Biomater. 2008, 4, 1038–1045. [Google Scholar] [CrossRef]
- Chopra, I.; Roberts, M. Tetracycline antibiotics: Mode of action, applications, molecular biology, and epidemiology of bacterial resistance. Microbiol. Mol. Biol. Rev. 2001, 65, 232–260. [Google Scholar] [CrossRef]
- Zakeri, B.; Wright, G.D. Chemical biology of tetracycline antibiotics. Biochem. Cell Biol. Biochim. Et Biol. Cell. 2008, 86, 124–136. [Google Scholar] [CrossRef]
- Gür, E.; Altinisik, A.; Yurdakoc, K. Preparation and characterization of chitosan/sepiolite bionanocomposites for tetracycline release. Polym. Compos. 2017, 38, 1810–1818. [Google Scholar] [CrossRef]
- Andrews, P. Praziquantel: Mechanisms of anti-schistosomal activity. Pharmacol. Ther. 1985, 29, 129–156. [Google Scholar] [CrossRef] [PubMed]
- Borrego-Sánchez, A.; Sánchez-Espejo, R.; García-Villén, F.; Viseras, C.; Sainz-Díaz, C.I. Praziquantel-Clays as Accelerated Release Systems to Enhance the Low Solubility of the Drug. Pharmaceutics 2020, 12, 914. [Google Scholar] [CrossRef] [PubMed]
- Bediako, E.G.; Nyankson, E.; Dodoo-Arhin, D.; Agyei-Tuffour, B.; Łukowiec, D.; Tomiczek, B.; Yaya, A.; Efavi, J.K. Modified halloysite nanoclay as a vehicle for sustained drug delivery. Heliyon 2018, 4, e00689. [Google Scholar] [CrossRef]
- Satish, S.; Tharmavaram, M.; Rawtani, D. Halloysite nanotubes as a nature’s boon for biomedical applications. Nanobiomedicine 2019, 6, 1849543519863625. [Google Scholar] [CrossRef]
- Cheng, C.; Song, W.; Zhao, Q.; Zhang, H. Halloysite nanotubes in polymer science: Purification, characterization, modification and applications. Nanotechnol. Rev. 2020, 9, 323–344. [Google Scholar] [CrossRef]
- Liu, H.; Wang, Z.-G.; Liu, S.-L.; Yao, X.; Chen, Y.; Shen, S.; Wu, Y.; Tian, W. Intracellular pathway of halloysite nanotubes: Potential application for antitumor drug delivery. J. Mater. Sci. 2019, 54, 693–704. [Google Scholar] [CrossRef]
- Peter, S.; Alven, S.; Maseko, R.B.; Aderibigbe, B.A. Doxorubicin-Based Hybrid Compounds as Potential Anticancer Agents: A Review. Molecules 2022, 27, 4478. [Google Scholar] [CrossRef]
- Damodar, G.; Smitha, T.; Gopinath, S.; Vijayakumar, S.; Rao, Y. An evaluation of hepatotoxicity in breast cancer patients receiving injection Doxorubicin. Ann. Med. Health Sci. Res. 2014, 4, 74–79. [Google Scholar] [CrossRef]
- Chhikara, B.S.; Mandal, D.; Parang, K. Synthesis, Anticancer Activities, and Cellular Uptake Studies of Lipophilic Derivatives of Doxorubicin Succinate. J. Med. Chem. 2012, 55, 1500–1510. [Google Scholar] [CrossRef]
- Li, K.; Zhang, Y.; Chen, M.; Hu, Y.; Jiang, W.; Zhou, L.; Li, S.; Xu, M.; Zhao, Q.; Wan, R. Enhanced antitumor efficacy of doxorubicin-encapsulated halloysite nanotubes. Int. J. Nanomed. 2018, 13, 19–30. [Google Scholar] [CrossRef] [PubMed]
- Ghanbari-Movahed, M.; Kaceli, T.; Mondal, A.; Farzaei, M.H.; Bishayee, A. Recent Advances in Improved Anticancer Efficacies of Camptothecin Nano-Formulations: A Systematic Review. Biomedicines 2021, 9, 480. [Google Scholar] [CrossRef] [PubMed]
- Dramou, P.; Fizir, M.; Taleb, A.; Itatahine, A.; Dahiru, N.S.; Mehdi, Y.A.; Wei, L.; Zhang, J.; He, H. Folic acid-conjugated chitosan oligosaccharide-magnetic halloysite nanotubes as a delivery system for camptothecin. Carbohydr. Polym. 2018, 197, 117–127. [Google Scholar] [CrossRef] [PubMed]
- Palem, R.R.; Rao, K.M.; Shimoga, G.; Saratale, R.G.; Shinde, S.K.; Ghodake, G.S.; Lee, S.-H. Physicochemical characterization, drug release, and biocompatibility evaluation of carboxymethyl cellulose-based hydrogels reinforced with sepiolite nanoclay. Int. J. Biol. Macromol. 2021, 178, 464–476. [Google Scholar] [CrossRef] [PubMed]
- Lisuzzo, L.; Wicklein, B.; Lo Dico, G.; Lazzara, G.; del Real, G.; Aranda, P.; Ruiz-Hitzky, E. Functional biohybrid materials based on halloysite, sepiolite and cellulose nanofibers for health applications. Dalton Trans. 2020, 49, 3830–3840. [Google Scholar] [CrossRef] [PubMed]
- Saleh, M.Y.; Prajapati, N.; DeCoster, M.A.; Lvov, Y. Tagged Halloysite Nanotubes as a Carrier for Intercellular Delivery in Brain Microvascular Endothelium. Front. Bioeng. Biotechnol. 2020, 8, 451. [Google Scholar] [CrossRef]
- Belete, T.M. The Current Status of Gene Therapy for the Treatment of Cancer. Biol. Targets Ther. 2021, 15, 67–77. [Google Scholar] [CrossRef]
- Howarth, J.L.; Lee, Y.B.; Uney, J.B. Using viral vectors as gene transfer tools (Cell Biology and Toxicology Special Issue: ETCS-UK 1 day meeting on genetic manipulation of cells). Cell Biol. Toxicol. 2010, 26, 1–20. [Google Scholar] [CrossRef]
- Zu, H.; Gao, D. Non-viral Vectors in Gene Therapy: Recent Development, Challenges, and Prospects. AAPS J. 2021, 23, 78. [Google Scholar] [CrossRef]
- Massaro, M.; Barone, G.; Biddeci, G.; Cavallaro, G.; Di Blasi, F.; Lazzara, G.; Nicotra, G.; Spinella, C.; Spinelli, G.; Riela, S. Halloysite nanotubes-carbon dots hybrids multifunctional nanocarrier with positive cell target ability as a potential non-viral vector for oral gene therapy. J. Colloid Interface Sci. 2019, 552, 236–246. [Google Scholar] [CrossRef]
- Long, Z.; Wu, Y.P.; Gao, H.Y.; Li, Y.F.; He, R.R.; Liu, M. Functionalization of Halloysite Nanotubes via Grafting of Dendrimer for Efficient Intracellular Delivery of siRNA. Bioconjugate Chem. 2018, 29, 2606–2618. [Google Scholar] [CrossRef] [PubMed]
- Persano, F.; Leporatti, S. Nano-Clays for Cancer Therapy: State-of-the Art and Future Perspectives. J. Pers. Med. 2022, 12, 1736. [Google Scholar] [CrossRef]
- Shi, Y.F.; Tian, Z.; Zhang, Y.; Shen, H.B.; Jia, N.Q. Functionalized halloysite nanotube-based carrier for intracellular delivery of antisense oligonucleotides. Nanoscale Res. Lett. 2011, 6, 608. [Google Scholar] [CrossRef] [PubMed]
- Wu, H.; Shi, Y.; Huang, C.; Zhang, Y.; Wu, J.; Shen, H.; Jia, N. Multifunctional nanocarrier based on clay nanotubes for efficient intracellular siRNA delivery and gene silencing. J. Biomater. Appl. 2014, 28, 1180–1189. [Google Scholar] [CrossRef] [PubMed]
- Mascarenhas-Melo, F.; Carvalho, A.; Gonçalves, M.B.S.; Paiva-Santos, A.C.; Veiga, F. Nanocarriers for the topical treatment of psoriasis—Pathophysiology, conventional treatments, nanotechnology, regulatory and toxicology. Eur. J. Pharm. Biopharm. 2022, 176, 95–107. [Google Scholar] [CrossRef]
- Nethi, S.K.; Das, S.; Patra, C.R.; Mukherjee, S. Recent advances in inorganic nanomaterials for wound-healing applications. Biomater. Sci. 2019, 7, 2652–2674. [Google Scholar] [CrossRef]
- Takeo, M.; Lee, W.; Ito, M. Wound healing and skin regeneration. Cold Spring Harb. Perspect. Med. 2015, 5, a023267. [Google Scholar] [CrossRef]
- Ridiandries, A.; Tan, J.T.M.; Bursill, C.A. The Role of Chemokines in Wound Healing. Int. J. Mol. Sci. 2018, 19, 3217. [Google Scholar] [CrossRef]
- Mascarenhas-Melo, F.; Peixoto, D.; Aleixo, C.; S. Gonçalves,, M.B.; Raza, F.; Pawar, K.D.; Veiga, F.; Liu, M.; Paiva-Santos, A.C. Nanoclays for wound management applications. Drug Deliv. Transl. Res. 2022. [Google Scholar] [CrossRef]
- Matter, M.T.; Probst, S.; Läuchli, S.; Herrmann, I.K. Uniting Drug and Delivery: Metal Oxide Hybrid Nanotherapeutics for Skin Wound Care. Pharmaceutics 2020, 12, 780. [Google Scholar] [CrossRef]
- Gould, L.; Abadir, P.; Brem, H.; Carter, M.; Conner-Kerr, T.; Davidson, J.; DiPietro, L.; Falanga, V.; Fife, C.; Gardner, S.; et al. Chronic wound repair and healing in older adults: Current status and future research. J. Am. Geriatr. Soc. 2015, 63, 427–438. [Google Scholar] [CrossRef] [PubMed]
- Louiselle, A.E.; Niemiec, S.M.; Zgheib, C.; Liechty, K.W. Macrophage polarization and diabetic wound healing. Transl. Res. J. Lab. Clin. Med. 2021, 236, 109–116. [Google Scholar] [CrossRef] [PubMed]
- Walgrave, S.E.; Warshaw, E.M.; Glesne, L.A. Allergic contact dermatitis from propolis. Dermat. Contact Atopic Occup. Drug 2005, 16, 209–215. [Google Scholar]
- Dutta, J.; Devi, N. Preparation, optimization, and characterization of chitosan-sepiolite nanocomposite films for wound healing. Int. J. Biol. Macromol. 2021, 186, 244–254. [Google Scholar] [CrossRef] [PubMed]
- Ul Ain, N.; Masood, F.; Noor, M.; Farooq, M. Fabrication and evaluation of antibacterial properties of Cu2O/sepiolite-PVA nanocomposite hydrogels against multidrug-resistant bacteria. Appl. Clay Sci. 2022, 229, 106663. [Google Scholar] [CrossRef]
- Feng, Y.; Luo, X.; Wu, F.; Liu, H.; Liang, E.; He, R.-R.; Liu, M. Systematic studies on blood coagulation mechanisms of halloysite nanotubes-coated PET dressing as superior topical hemostatic agent. Chem. Eng. J. 2022, 428, 132049. [Google Scholar] [CrossRef]
- Kouser, S.; Prabhu, A.; Sheik, S.; Prashantha, K.; Nagaraja, G.K.; Neetha D’souza, J.; Navada, K.M.; Manasa, D.J. Chitosan functionalized halloysite nanotube/poly (caprolactone) nanocomposites for wound healing application. Appl. Surf. Sci. Adv. 2021, 6, 100158. [Google Scholar] [CrossRef]
- Stavitskaya, A.; Batasheva, S.; Vinokurov, V.; Fakhrullina, G.; Sangarov, V.; Lvov, Y.; Fakhrullin, R. Antimicrobial Applications of Clay Nanotube-Based Composites. Nanomaterials 2019, 9, 708. [Google Scholar] [CrossRef]
- Li, D.; Liu, P.; Hao, F.; Lv, Y.; Xiong, W.; Yan, C.; Wu, Y.; Luo, H.A. Preparation and application of silver/chitosan-sepiolite materials with antimicrobial activities and low cytotoxicity. Int. J. Biol. Macromol. 2022, 210, 337–349. [Google Scholar] [CrossRef]
- Li, D.; Huang, X.; Hao, F.; Lv, Y.; Chen, H.; Wu, S.; Xiong, W.; Liu, P.; Luo, H.A. Preparation of organic-inorganic composites with high antibacterial activity based on sepiolite, chitosan and zinc: The study of the active antibacterial sites of chitosan-zinc oxide structure. Appl. Clay Sci. 2022, 216, 106325. [Google Scholar] [CrossRef]
- Biddeci, G.; Cavallaro, G.; Di Blasi, F.; Lazzara, G.; Massaro, M.; Milioto, S.; Parisi, F.; Riela, S.; Spinelli, G. Halloysite nanotubes loaded with peppermint essential oil as filler for functional biopolymer film. Carbohydr. Polym. 2016, 152, 548–557. [Google Scholar] [CrossRef] [PubMed]
- Boro, U.; Moholkar, V.S. Antimicrobial bionanocomposites of poly(lactic acid)/ZnO deposited halloysite nanotubes for potential food packaging applications. Mater. Today Commun. 2022, 33, 104787. [Google Scholar] [CrossRef]

Disclaimer/Publisher’s Note: The statements, opinions and data contained in all publications are solely those of the individual author(s) and contributor(s) and not of MDPI and/or the editor(s). MDPI and/or the editor(s) disclaim responsibility for any injury to people or property resulting from any ideas, methods, instructions or products referred to in the content. |
© 2023 by the authors. Licensee MDPI, Basel, Switzerland. This article is an open access article distributed under the terms and conditions of the Creative Commons Attribution (CC BY) license (https://creativecommons.org/licenses/by/4.0/).
Share and Cite
Biddeci, G.; Spinelli, G.; Colomba, P.; Di Blasi, F. Halloysite Nanotubes and Sepiolite for Health Applications. Int. J. Mol. Sci. 2023, 24, 4801. https://doi.org/10.3390/ijms24054801
Biddeci G, Spinelli G, Colomba P, Di Blasi F. Halloysite Nanotubes and Sepiolite for Health Applications. International Journal of Molecular Sciences. 2023; 24(5):4801. https://doi.org/10.3390/ijms24054801
Chicago/Turabian StyleBiddeci, Giuseppa, Gaetano Spinelli, Paolo Colomba, and Francesco Di Blasi. 2023. "Halloysite Nanotubes and Sepiolite for Health Applications" International Journal of Molecular Sciences 24, no. 5: 4801. https://doi.org/10.3390/ijms24054801
APA StyleBiddeci, G., Spinelli, G., Colomba, P., & Di Blasi, F. (2023). Halloysite Nanotubes and Sepiolite for Health Applications. International Journal of Molecular Sciences, 24(5), 4801. https://doi.org/10.3390/ijms24054801

